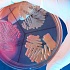
Пищевое отравление новорожденный получил от матери

Алкоголь
Бакалея
Выставки и фестивали
Детское питание
Еда для животных
Кондитерская
Кухонная техника
Магазины
Молочные продукты
Мясные продукты
Напитки и соки
Охлаждение
Прочие новости
Рыбная и морепродукция
Сельское хозяйство
Скандалы и происшествия
Упаковка
Фрукты и овощи
Хлеб и выпечка
Последние новости раздела: Скандалы и происшествия
Самое читаемое по этой теме:
Рецепты
Тело
Самое читаемое:
Если регулярно пить эти напитки, Вы гарантированно похудеете!
Как сжечь лишний жир без спортзала и диет!
Этот напиток быстро сжигает избыток жира на вашей талии и бедрах!
Принимайте эту смесь 2 раза в день и быстро худейте без физической нагрузки!
Худеем без особых усилий, употребляя каждый день чудо-салат!
Забудьте о силиконе! Шесть растений, которые способствуют росту груди